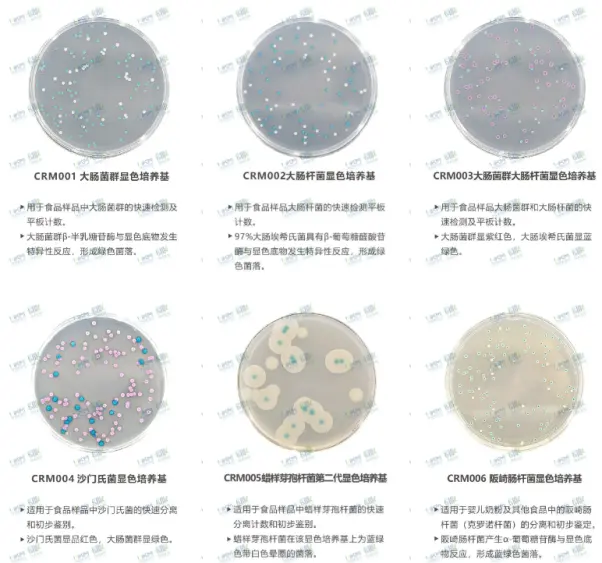
环凯显色培养基系列 环凯显色培养基系列

市场监管总局通报43批次食品不合格 | 微生物污染成重灾区,环凯检测解决方案助力防控
发布时间:2026-03-26 浏览次数:973 分享:
3月20日,国家市场监督管理总局办公厅发布《关于43批次食品抽检不合格情况的通报》,本次组织食品安全监督抽检2252批次样品,共检出43批次样品不合格,覆盖糕点、蔬菜制品、水果制品、饮料、肉制品、餐饮食品、特殊膳食食品等多个民生高频品类,相关省级市场监管部门已对不合格食品全面启动核查处置。
在本次通报的不合格项目中,微生物污染问题尤为突出,成为本次抽检不合格的核心重灾区。多批次产品被检出菌落总数、大肠菌群数、霉菌数等微生物指标不符合食品安全国家标准规定,覆盖生产、流通、餐饮全环节,再次为全国食品生产经营企业敲响了食品安全与合规经营的警钟。

一、通报直击:这些品类,微生物超标问题频发
梳理本次官方通报,微生物指标不合格的问题贯穿食品产业链上下游,多个大众日常消费品类上榜:
饮料品类:椰子水、沙棘原浆等产品,分别被检出菌落总数、霉菌数项目不符合国标规定;
肉制品品类:无骨鸡爪、佤味鸡爪等产品,分别被检出大肠菌群数、菌落总数项目超标;
方便食品品类:奇亚籽坚果藕粉等产品被检出霉菌数不符合食品安全国家标准;
膏滋类食品:伏湿膏等产品菌落总数不符合相关产品执行标准要求;
餐饮环节:餐饮店自行消毒的复用餐饮具,被检出大肠菌群数不合格。

二、微生物超标,代价远比想象的更沉重
很多食品企业会问:微生物指标不合格,到底会带来哪些不可逆转的影响?
对消费者而言,微生物污染是食品安全的核心风险源:
菌落总数超标,直接反映产品整体卫生状况失控,不仅会加速产品腐败变质,严重时还可能引发恶心、腹泻等肠胃不适;
大肠菌群超标,是产品被肠道致病菌污染的重要警示信号,存在引发食源性疾病的明确风险;
霉菌超标,不仅会破坏食品营养成分、导致产品变质,部分霉菌还会产生强毒性真菌毒素,长期摄入会对人体肝脏等器官造成不可逆损伤。
对食品生产经营企业而言,微生物指标不合格的代价更是难以估量:
产品被全国通报、强制下架召回,直接造成巨额经济损失;
面临监管部门的核查处置与行政处罚,合规成本大幅上升;
品牌口碑与消费者信任度严重受损,多年积累的品牌形象可能一朝崩塌。
三、筑牢食药安全防线,环凯全系列微生物检测解决方案
深耕微生物监测控制领域二十余年,广东环凯微生物科技有限公司始终以“为食药安全保驾护航” 为核心使命,针对食品行业微生物管控的核心痛点,打造全系列、全场景的微生物检测产品与解决方案,助力食品生产经营企业精准把控微生物风险,守住产品合规底线,远离抽检不合格风险。
1、精准监测:国标级微生物检测试剂,精准锁定全品类微生物风险
及时、准确地发现微生物污染源是第一步。环凯提供符合GB4789系列国家标准的全线微生物检测产品,助力企业高效完成出厂检验和环境监测。
环凯显色培养基系列:针对大肠杆菌、沙门氏菌、蜡样芽孢杆菌等致病菌,显色反应灵敏直观,结果判读快速准确,有效缩短检测周期,提升检测效率。
环凯干燥培养基系列:采用优质原料,性能稳定,批间差小,确保检测结果的准确性和重现性,是实验室日常检测的可靠选择。

环凯微生物快速检测试片:操作简便,无需复杂配制,即开即用,尤其适合企业现场快速筛查和半定量检测,帮助您第一时间掌握卫生状况。

2、全流程配套产品与耗材:打造闭环式微生物质控体系
除核心检测试剂外,环凯微生物还提供微生物检测全流程配套产品与耗材,为企业打造完整、规范的微生物检测质控体系,从源头规避污染风险:

无菌采样与前处理耗材:涵盖无菌均质袋、采样管、一次性无菌接种环等全品类产品,从采样源头保障检测结果的准确性,杜绝交叉污染;
生产环境监测产品:针对食品生产车间洁净度管控,提供沉降菌、浮游菌检测配套产品,帮助企业实时把控生产环境的微生物水平,从生产端降低污染风险。
食品安全无小事,每一次抽检通报,都是对行业的一次警醒。未来,环凯微生物将持续深耕微生物监测控制领域,以更优质的产品、更专业的解决方案,携手广大食品生产经营企业,共同筑牢食药安全防线,守护千家万户“舌尖上的安全”。
参考信息:市场监管总局办公厅关于43批次食品抽检不合格情况的通报——市监食检发〔2026〕20号。
